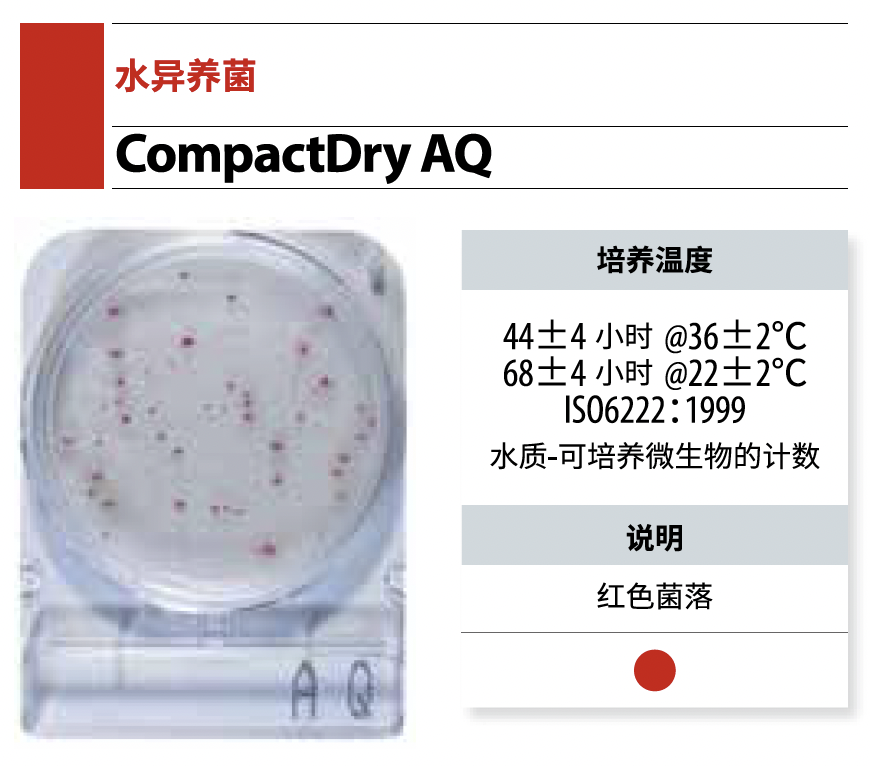
圖片

01
檢測標(biāo)準(zhǔn)
銅綠假單胞菌是水質(zhì)監(jiān)測的篩查指標(biāo)(如食品安全國家標(biāo)準(zhǔn) 飲用天然礦泉水》(GB 8537-2018)、《食品安全國家標(biāo)準(zhǔn) 包裝飲用水》(GB 19298-2014)的微生物限量中規(guī)定銅綠假單胞菌“n=5,c=0,m=0(CFU/250 mL)",均不得檢出銅綠假單胞菌),目前市場銷售的飲用水有飲用天然礦泉水、飲用純凈水和其他類飲用水等均需檢測。
但檢測到該菌的存在傳統(tǒng)方法膜過濾→假單胞菌瓊脂(CN 瓊脂)→42 ℃/48 h→氧化酶陽性→確證,操作鏈長、周期長,單批次檢測綜合成本高,痛點(diǎn)疊加,催生了“更快、更準(zhǔn)"的檢測需求——這正是島津 Compact Dry PA銅綠假單胞菌測試片誕生的背景,為行業(yè)帶來“快、準(zhǔn)、穩(wěn)"的一站式解決方案。

02
島津解決方案
島津Compact Dry PA銅綠假單胞菌測試片是一種基于顯色培養(yǎng)基的定量檢測方法,通過直接加樣或過濾水樣并在特定培養(yǎng)基上培養(yǎng),能夠快速檢測并計(jì)數(shù)銅綠假單胞菌。水樣(100ml或250ml)通過膜過濾系統(tǒng)過濾到預(yù)先潤濕的測試片并放置在其上,在36±1°C下孵育48小時±3小時(最快24小時可報(bào)告陽性結(jié)果),目標(biāo)微生物以帶有黃色/綠色光環(huán)的紅色菌落或藍(lán)綠色菌落生長。

03
島津測試片產(chǎn)品優(yōu)勢

類平皿設(shè)計(jì),密封性良好

自動擴(kuò)散,無樣品外溢風(fēng)險

即開即用,方便現(xiàn)場實(shí)際檢測操作

多種使用方法,可直接加樣或
配合膜過濾方法使用
歐盟測試機(jī)構(gòu)MicroVal基于ISO 17994-2014和ISO 16149-2:2016驗(yàn)證了Compact Dry PA驗(yàn)證范圍包括 5 種不同類型的水樣,該方法在相對真值、準(zhǔn)確性、選擇性、特異性和不同實(shí)驗(yàn)室間的比對數(shù)據(jù)均表現(xiàn)出良好的性能。
Compact Dry PA方法在飲用水微生物檢測中的應(yīng)用提供了科學(xué)依據(jù),有助于提高檢測效率和準(zhǔn)確性,同時為水質(zhì)安全管理提供了技術(shù)支持。

島津CompactDry
水質(zhì)檢測相關(guān)微生物測試片

腸球菌快速檢測



水異養(yǎng)菌快速檢測

更多產(chǎn)品請點(diǎn)擊查看產(chǎn)品目錄



(空格分隔,最多3個,單個標(biāo)簽最多10個字符)
立即詢價
您提交后,專屬客服將第一時間為您服務(wù)